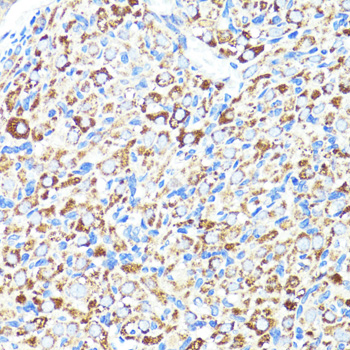
Immunohistochemistry - CNR1 Polyclonal Antibody
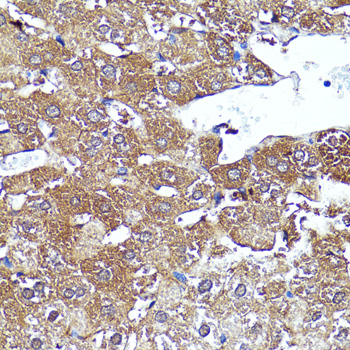
Immunohistochemistry - CNR1 Polyclonal Antibody

-
Product Name
CNR1 Polyclonal Antibody
- Documents
-
Description
Polyclonal antibody to CNR1
-
Tested applications
WB, IHC
-
Species reactivity
Human, Mouse, Rat
-
Alternative names
CNR1 antibody; CANN6 antibody; CB-R antibody; CB1 antibody; CB1A antibody; CB1K5 antibody; CB1R antibody; CNR antibody; cannabinoid receptor 1 antibody
-
Isotype
Rabbit IgG
-
Preparation
Antigen: Recombinant fusion protein containing a sequence corresponding to amino acids 1-120 of human CNR1 (NP_001153731.1).
-
Clonality
Polyclonal
-
Formulation
PBS with 0.02% sodium azide, 50% glycerol, pH7.3.
-
Storage instructions
Store at -20℃. Avoid freeze / thaw cycles.
-
Applications
WB 1:500 - 1:2000
IHC 1:50 - 1:100 -
Validations

Western blot - CNR1 Polyclonal Antibody
Western blot analysis of extracts of NIH3T3 cells, using CNR1 antibody at 1:1000 dilution.Secondary antibody: HRP Goat Anti-Rabbit IgG (H+L) at 1:10000 dilution.Lysates/proteins: 25ug per lane.Blocking buffer: 3% nonfat dry milk in TBST.Detection: ECL Enhanced Kit .Exposure time: 60s.

Immunohistochemistry - CNR1 Polyclonal Antibody
Immunohistochemistry of paraffin-embedded human lung cancer using CNR1 antibody at dilution of 1:150 (40x lens).

Immunohistochemistry - CNR1 Polyclonal Antibody
Immunohistochemistry of paraffin-embedded human stomach cancer using CNR1 antibody at dilution of 1:150 (40x lens).

Immunohistochemistry - CNR1 Polyclonal Antibody
Immunohistochemistry of paraffin-embedded mouse kidney using CNR1 antibody at dilution of 1:150 (40x lens).
Immunohistochemistry - CNR1 Polyclonal Antibody
Immunohistochemistry of paraffin-embedded rat ovary using CNR1 antibody at dilution of 1:150 (40x lens).
Immunohistochemistry - CNR1 Polyclonal Antibody
Immunohistochemistry of paraffin-embedded rat liver using CNR1 antibody at dilution of 1:150 (40x lens).
-
Background
G-protein coupled receptor for endogenous cannabinoids (eCBs), including N-arachidonoylethanolamide (also called anandamide or AEA) and 2-arachidonoylglycerol (2-AG), as well as phytocannabinoids, such as delta(9)-tetrahydrocannabinol (THC). Mediates many cannabinoid-induced effects, acting, among others, on food intake, memory loss, gastrointestinal motility, catalepsy, ambulatory activity, anxiety, chronic pain. Signaling typically involves reduction in cyclic AMP. In the hypothalamus, may have a dual effect on mitochondrial respiration depending upon the agonist dose and possibly upon the cell type. Increases respiration at low doses, while decreases respiration at high doses. At high doses, CNR1 signal transduction involves G-protein alpha-i protein activation and subsequent inhibition of mitochondrial soluble adenylate cyclase, decrease in cyclic AMP concentration, inhibition of protein kinase A (PKA)-dependent phosphorylation of specific subunits of the mitochondrial electron transport system, including NDUFS2. In the hypothalamus, inhibits leptin-induced reactive oxygen species (ROS) formation and mediates cannabinoid-induced increase in SREBF1 and FASN gene expression. In response to cannabinoids, drives the release of orexigenic beta-endorphin, but not that of melanocyte-stimulating hormone alpha/alpha-MSH, from hypothalamic POMC neurons, hence promoting food intake. In the hippocampus, regulates cellular respiration and energy production in response to cannabinoids. Involved in cannabinoid-dependent depolarization-induced suppression of inhibition (DSI), a process in which depolarization of CA1 postsynaptic pyramidal neurons mobilizes eCBs, which retrogradely activate presynaptic CB1 receptors, transiently decreasing GABAergic inhibitory neurotransmission. Also reduces excitatory synaptic transmission (By similarity). In superior cervical ganglions and cerebral vascular smooth muscle cells, inhibits voltage-gated Ca(2+) channels in a constitutive, as well as agonist-dependent manner. In cerebral vascular smooth muscle cells, cannabinoid-induced inhibition of voltage-gated Ca(2+) channels leads to vasodilation and decreased vascular tone (By similarity). Induces leptin production in adipocytes and reduces LRP2-mediated leptin clearance in the kidney, hence participating in hyperleptinemia. In adipose tissue, CNR1 signaling leads to increased expression of SREBF1, ACACA and FASN genes (By similarity). In the liver, activation by endocannabinoids leads to increased de novo lipogenesis and reduced fatty acid catabolism, associated with increased expression of SREBF1/SREBP-1, GCK, ACACA, ACACB and FASN genes. May also affect de novo cholesterol synthesis and HDL-cholesteryl ether uptake. Peripherally modulates energy metabolism (By similarity). In high carbohydrate diet-induced obesity, may decrease the expression of mitochondrial dihydrolipoyl dehydrogenase/DLD in striated muscles, as well as that of selected glucose/ pyruvate metabolic enzymes, hence affecting energy expenditure through mitochondrial metabolism (By similarity). In response to cannabinoid anandamide, elicits a proinflammatory response in macrophages, which involves NLRP3 inflammasome activation and IL1B and IL18 secretion (By similarity). In macrophages infiltrating pancreatic islets, this process may participate in the progression of type-2 diabetes and associated loss of pancreatic beta-cells.; Isoform 1: Binds both 2-AG and anandamide.; Isoform 2: Only binds 2-AG with high affinity. Contrary to its effect on isoform 1, 2-AG behaves as an inverse agonist on isoform 2 in assays measuring GTP binding to membranes.; Isoform 3: Only binds 2-AG with high affinity. Contrary to its effect on isoform 1, 2-AG behaves as an inverse agonist on isoform 3 in assays measuring GTP binding to membranes.
Related Products / Services
Please note: All products are "FOR RESEARCH USE ONLY AND ARE NOT INTENDED FOR DIAGNOSTIC OR THERAPEUTIC USE"
